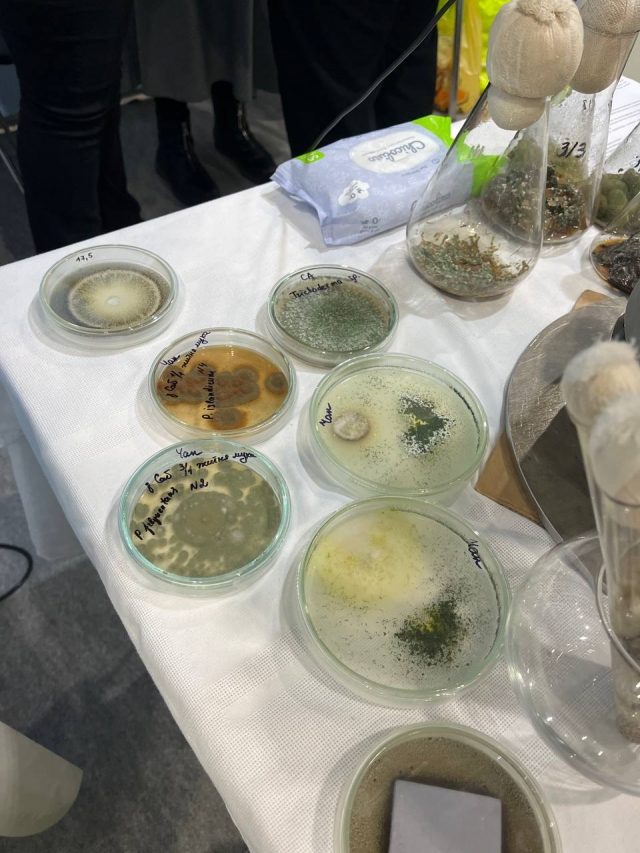

«Міжнародна виставка інноваційних рішень у зерновому господарстві»
Normal
0
21
false
false
false
UK
X-NONE
X-NONE
15 лютого студенти Агробіологічного факультету мали чудову можливість відвідати міжнародну агропромислову виставку «Зернові технології», яка посідає головне місце серед спеціалізованих виставкових заходів України та спрямована на просування інноваційних рішень на різних стадіях виробництва, зберігання, переробки та транспортування зернових, бобових, круп'яних та олійних культур.

Сенат студентської організації на чолі з Максимом Середюком та Ярославом Мостовим переконані, що подібні заходи є вагомими ключовими аспектами в навчанні молодих спеціалістів. Саме завдяки ініціативі адміністрації та ССО факультету наші студенти були проінформовані та замотивовані до колективного відвідування заходу, адже це чудова можливість дізнатися про сучасні тенденції аграрного сектору та тренди на ринку України.

Агропромислова виставка об’єднує провідних постачальників обладнання, дилерів та представників виробничого сектору як зернового ринку України, так і компанії міжнародного формату.

Це гарна можливість для діалогу між виробниками технологічних рішень, фахівцями сільськогосподарських підприємств та безпосередньо нашими майбутніми агрономами.


На агропромисловій виставці «Зернові технології» студентство мало можливість ознайомитися з обладнанням для зберігання та переробки зернових та олійних культур, виробництвом комбікормів, обладнанням для елеваторів та хлібоприймальних пунктів, мукомельної, круп’яної промисловості, насіннєвий матеріал, засоби захисту рослин, лабораторним та ваговимірювальним обладнанням, технікою та технологіями для виробництва зернової продукції.



Ще однією перевагою виставки є насичена ділова програма, яка включає галузеві форуми, конференції, семінари та майстер-класи.


Варто зазначити, що практичне ознайомлення студентів з аграрним напрямком є дуже цінним в наш час, подібні заходи надзвичайно необхідні для всебічного розвитку студентів Агробіологічного факультету.
Студенти отримали надзвичайну кількість нових вражень та інформації, що ще більше замотивувала молодь до навчання.


«На мою думку, на виставці було представлено найсучасніші технології всіх етапів виробництва, зберігання, переробки та транспортування зернових, бобових, круп’яних та олійних культур. Я була вражена різноманіттям обладнання та інновацій, які допомагають підвищити продуктивність та якість сільськогосподарської продукції. Мою особисту увагу привернула кількість представлених агродронів, галузь яких розвивається навіть попри війну та її обмеження. Захід продемонстрував високий рівень співпраці між фахівцями сфери. Було надзвичайно цікаво та корисно!» - поділилася враженнями студентка 2 курсу 9 групи Вікторія Джевага.



Сенат студентської організації дуже зацікавлений в відвідуванні даних заходів, важливим моментом є те що квитки на виставку були безкоштовні за попередньою онлайн реєстрацією, це велика рідкість і вагома перевага. Продовжуємо пошуки подібних виставкових експозицій, готові до співпраці!
Любов Тхорик,
Голова Сенату студентської організації агробіологічного факультету НУБІП України